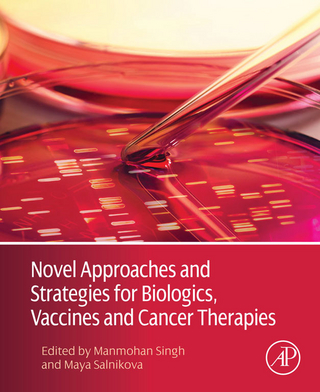
Novel Approaches and Strategies for Biologics, Vaccines and Cancer Therapies

Advances in Nanotechnology, Drug Delivery, and Therapy
eBook Download (PDF)
2014
|
Pan Stanford Publishing
ISBN: 9789814411202
374,60 €
(CHF 359,95) (inkl. MwSt)
(CHF 359,95) (inkl. MwSt)
- Download sofort lieferbar